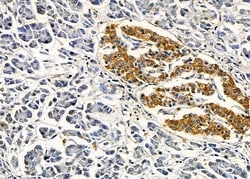
Invitrogen IFNA7/IFNA16 Polyclonal Antibody 100 &mu;L; Unconjugated:Antibodies,

missing translation for 'onlineSavingsMsg'
Learn More
Learn More
Invitrogen™ IFNA7/IFNA16 Polyclonal Antibody


Rabbit Polyclonal Antibody
Brand: Invitrogen™ PA5103423
This item is not returnable.
View return policy
Description
Antibody detects endogenous levels of total IFNA7/16.
IFNA7 (Interferon Alpha 7) and IFNA16 (Interferon Alpha 16) are predicted to enable cytokine activity and type I interferon receptor binding activity and to be involved in several processes, including B cell activation; lymphocyte activation involved in immune response; and positive regulation of peptidyl-serine phosphorylation of STAT protein.
Specifications
| IFNA7/IFNA16 | |
| Polyclonal | |
| Unconjugated | |
| IFNA7 | |
| Interferon | |
| Rabbit | |
| Affinity chromatography | |
| RUO | |
| 3444, 3449 | |
| -20°C | |
| Liquid |
| Immunohistochemistry (Paraffin), Western Blot, Immunocytochemistry | |
| 1 mg/mL | |
| PBS with 50% glycerol and 0.02% sodium azide; pH 7.4 | |
| P01567, P05015 | |
| IFNA16, IFNA7 | |
| A synthesized peptide derived from human IFNA16(Accession P05015), corresponding to amino acid residues G33-M83. | |
| 100 μL | |
| Primary | |
| Human | |
| Antibody | |
| IgG |
Product Content Correction
Your input is important to us. Please complete this form to provide feedback related to the content on this product.
Product Title
Spot an opportunity for improvement?Share a Content Correction